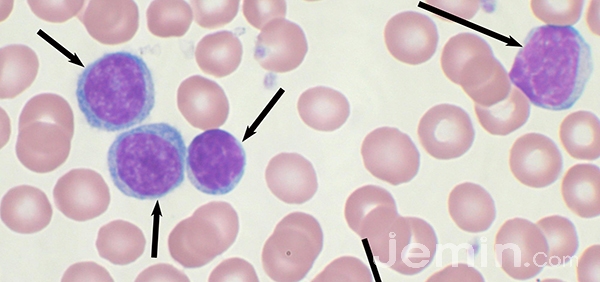

제민일보-제주한라병원-제주근로자건강센터 공동기획 근로자의 LOHAS LIFE를 꿈꾸며 10. 백혈병과 조혈모세포 이식
혈액암 전체 암질환의 5% 이내 차지 희귀암 일종
골수이식 경우 거부반응·이식편대숙주반응 장벽
△2000년 이후 증가 추세
국민건강보험 일산병원 연구소에 따르면 혈액암은 전체 암질환의 5% 이내를 차지하는 희귀암의 일종이지만 2000년 이후 전체적으로 혈액암 환자의 숫자가 꾸준하게 증가하는 추세를 보이고 있다.
혈액암의 종류로는 다발성골수종 및 악성형질세포신생물(진단코드 C90), 림프성 백혈병(진단코드 C91), 골수성 백혈병(진단코드 C92-94) 등이 있다. 제주지역의 경우 골수성 백혈병이 가장 높은 유병률을 차지하고 빈도는 2005년 76명이던 것이 2015년에는 183명으로 늘어났다.
혈액암의 경우 고형암과 달리 수술로 제거할 수 없는 암종으로 오랫동안 마땅한 치료제가 없어 불치병으로 통해 환자들이 고통을 받아왔다.
하지만 1950년대 미국에서 개발된 메토트렉세이트(MTX)를 시작으로 항암제 치료의 막을 올렸다. 1970년 들어 미국에서 골수이식이 성공하면서 혈액암 치료는 또 다른 전기를 맞았다.
콩팥이나 간 등 병든 고형장기를 다른 사람의 장기로 대체하는 이식치료는 그 이전부터 실시됐으나 골수이식의 경우 완전히 정착되기까지는 난관이 많았고, 이를 극복하기 위한 여러 유관기술의 발전이 필요했다.
△조직적합성 항원 확인
혈액암 환자가 타인의 골수를 이식받는 경우 넘어야 할 두 개의 장벽이 거부반응(Rejection)과 이식편대숙주반응(GVHD)이다.
이를 적절하게 조절해 생착(타인의 골수세포가 환자의 골수에 성공적으로 안착하는 것)을 유도하려면 조직적 합성항원(HLA), 항암제, 면역억제제, 혈소판 등의 수혈, 항생제 등에 대한 충분한 이해와 관련 시설, 인력이 필요하다.
조금 더 부연하면 이식가능한 골수를 찾기 위해 혈액형뿐만 아니라 백혈구 항원인 조직적합성 항원이 서로 맞는지 확인해야 한다. 이 과정이 끝나면 적합한 공여자로부터 골수를 채취해 조혈줄기세포가 충분한지 확인한 후 환자에게 투여를 진행한다.
그 전에 환자는 병든 골수에 있는 백혈병 세포를 제거하기 위해 항암제나 방사선 조사를 실시해야 한다.
타인의 골수를 이식 받은 후에는 완전히 생착되기 전에 과도기적으로 발생하는 혈소판 감소를 위해 혈소판 수혈이 필요하고 이식편대숙주반응(타인의 골수에 있는 면역세포에 의해 환자의 소화관이나 피부, 간 등에 염증이 일어나는 치명적인 자가면역반응)을 피하기 위해 면역억제제와 함께 항생제를 투여해 부작용인 감염을 막는다. 이 모든 이식 과정이 끝나면 새로 생착한 골수이기 때문에 이식을 받은 환자는 신생아처럼 예방접종을 다시 해야 한다.
△전문인력 및 시설 필요
우리나라의 경우 가톨릭대 서울성모병원 의료진들이 개를 이용한 전임상시험을 거친 후 1983년에 드디어 사람의 동종골수이식에 성공했다. 이후 다른 수도권 병원에서도 점진적으로 골수이식이 시행되기 시작했다.
제주도의 경우는 2000년 이후 제주한라병원에서 준비하기 시작했고, 2010년에 도내에서 최초로 자가말초조혈모세포이식에 성공했다. 이어 2017년에 다시 타인으로부터 조혈모세포를 제공받아 시술하는 비혈연간 동종조혈모세포이식을 성공적으로 마쳤다.
지난해에는 한 해 동안 무려 3차례나 안정적으로 비혈연간 동종조혈모세포이식을 수행함으로써 도내에선 유일하게 자가말초조혈모세포이식(환자 자신의 골수를 냉동시켜놓았다가 고용량 항암요법을 실시 후 투여받는 요법)과 동종조혈모세포이식(건강한 타인의 골수를 이식받는 요법으로 자가골수이식보다는 난이도가 훨씬 높다)을 안정적으로 실시하고 있다.
특히 비혈연간 동종조혈모세포이식이 가능한 병원은 국내에서 열손가락으로 꼽을 수 있는 정도다.
골수이식을 안정적으로 유지하기 위해서는 무균실, 방사선 치료시설, 혈액은행, 검사실 등이 필요하고 혈액내과, 진단검사의학과, 방사선종양학과, 감염내과, 항암병동 등의 전문인력과 시설이 꾸준히 높은 품질로 유지돼야 한다.
아직은 희귀종양인 혈액암의 빈도를 생각하면 상대적으로 유지비용이 많다는 어려움이 있다.
그럼에도 불구하고 제주한라병원은 제주도민의 의료접근성을 높이고 의료기술 부족으로 수도권을 오르락내리락 하는 해야 하는 불편함을 없애기 위해 의료수준을 높이는데 집중하고 있다. 한 권 기자

■도움말=김우진 제주한라병원 진단검사의학과장 / 민우성 제주한라병원 혈액종양내과장
올바른 자세와 스트레칭으로 VDT증후군 예방 |
| VDT(Visual Displat Terminal Syndrome)증후군은 영상화면 단말기의 장시간 사용으로 유발되는 질환을 총칭한다. 업무적으로 컴퓨터 사용이 많은 근로자에게 주로 발병되고 있어 일종의 직업병으로도 불린다. 근막통증증후군, 손목터널증후군, 허리·목디스크, 거북목증후군, 안구건조증 등이 대표적 증상으로 성별과 연령을 불문해 나타나며, 업무 스트레스가 겹치면 그 피해는 더 커진다. 따라서 전문가들은 VDT증후군 예방을 위해 올바른 자세와 스트레칭을 강조한다. 가장 기본적으로 의자에 앉을 때는 등받이에 엉덩이를 밀착시켜 허리를 곧게 편 채로 앉고, 모니터와 눈의 거리는 40㎝ 이상 유지하는 게 좋다. 팔꿈치는 책상에 가볍게 내려놓되 그 각도가 90~110도를 유지하는 것이 좋다. 무릎은 90~100도를 유지하면서 발바닥 전체가 땅에 닿도록 해야 한다. 또 한 시간 동안 업무에 집중했다면 최소 10분은 쉬어야 한다. 한 자세로 오랫동안 같은 자세를 유지하다보면 자신도 모르게 근육들이 긴장하게 되는데, 이로 인해 목, 어깨, 허리 등 근육이 뭉치게 되고 피로를 유발하게 되는 것이다. 휴식하는 동안에는 스트레칭을 하는 등 경직된 근육을 풀어주고, 먼 산을 바라보거나 잠시 눈을 감는 등 눈에도 휴식을 주는 것이 필요하다. 매일 컴퓨터로 작업을 하는 직장인의 경우에는 이러한 증상을 예방하기 위해 올바른 자세와 함께 스트레칭을 생활화하고 지속적인 관리가 필요하다. 집이나 사무실에서도 간단히 할 수 있는 스트레칭 동작을 소개한다. 어깨 스트레칭은 한쪽 팔을 어깨 위로 올려 뒤로 구부리고 반대편 손으로 팔꿈치를 지그시 눌러준다. 평소 충분히 정확하게 반복하면 어깨 결림이나 근육통을 예방할 수 있다. 등허리 스트레칭은 양팔을 어깨 위로 세우고 한쪽으로 구부려 허리근육을 길게 늘려준다. 일상에서 가장 많이 긴장하는 부분으로 등과 허리 스트레칭으로 하루를 정돈하면 몸이 한결 여유롭다. 하체 스트레칭은 한쪽 다리는 앞으로 구부리고 반대쪽 다리는 뒤로 곧게 뻗어 약간의 통증이 느껴질 때까지 자세를 유지한다. 앞의 다리는 무릎이 발끝을 넘지 않아야 무릎으로 가는 체중의 부담을 줄일 수 있다. 손목 스트레칭은 앞으로 나란히 팔을 뻗어 손바닥을 세운 뒤 한쪽 손으로 반대편 손의 손가락 부위를 지그시 몸쪽으로 당긴다. 일상에서 피로가 많이 누적되는 부위이므로 충분한 스트레칭으로 근육을 바로바로 풀어주는 것이 좋다. 제주근로자건강센터는 근로자에게 노출되는 근골격계질환 예방을 위한 스트레칭 교육을 무료로 지원하고 있다. 건강상담문의=064-752-8961(제주시 중앙로 165 고용복지플러스센터), 064-745-8961(연동 분소, 제주시 수목원길 9 근로자종합복지관) |


